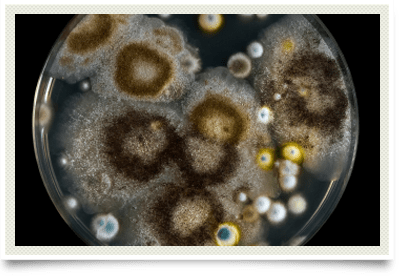

Mold Allergy
and Where It Thrives
Mold spores are produced from fungi when the humidity is in excess of 65%. Fungi thrive in deeply shaded niches, on moist soil or other leaf surfaces, and any other moist environment. This can also occur in homes where a water leak is present. Due to the lack of deep rivers and lakes and a relative lack of rainfall, mold allergy is not as prevalent as pollen allergy in central Oklahoma.
Alternaria, Aspergillus, Cladosporium, Helmithosporium, and Penicillium are the most frequently encountered molds. They colonize dying or dead plants. They are also present on food, moist window frames, home with poor ventilation, and in low, damp areas. They inhabit soils, rotten wood, bird nests, composts, and silos. Any stored foods such as grains, hay, bread, fruit, cheese, nuts, and other plants can harbor mold. These are considered environmental molds.
The black mold in buildings is usually Stachybotrys. This was formally known as mildew and it is found in homes with excessive moisture and water leaks. This mold should be managed by removal.
